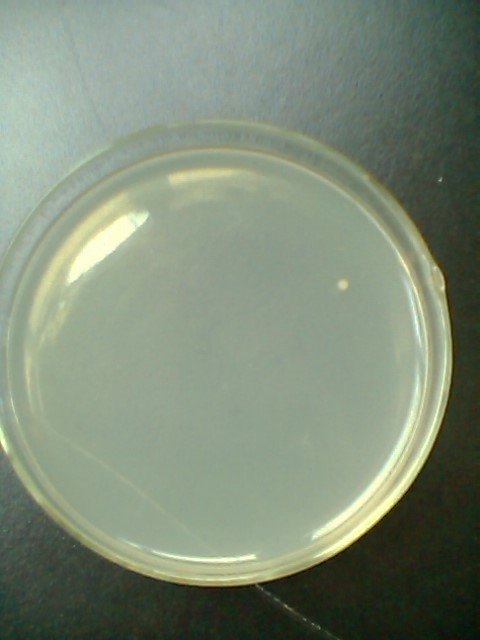
增值培养基

空白培养基

所有分类 制备和转化感受态大肠杆菌的inoue方法总结 图c 空白对照
图片尺寸523x512
这个是什么细菌?在牛肉膏蛋白胨培养基上生长的.
图片尺寸500x375
空白培养皿照片
图片尺寸300x300
p>培养基,是指供给微生物,植物或动物(或组织)生长繁殖的,由不同营养
图片尺寸640x480
增值培养基
图片尺寸480x640
pdf培养基
图片尺寸720x1280
图4:酸溜溜抑菌试验(lb培养基;作用3小时),从左到右平皿分别对应:空白
图片尺寸800x295
图2 样品c空白对照组和实验组(lb培养基;作用3小时)?
图片尺寸1280x347
为什么我的bg11培养基会有这样一层白色的东西
图片尺寸900x675
空白培养基 一级种试管种复壮培养基试管纯培养基空白试管 培养基
图片尺寸750x750
培养基空白长菌,如何处理?
图片尺寸2485x2326
lb营养琼脂250g
图片尺寸650x212
改良msrv培养基的原理和使用方法
图片尺寸2000x1299
用蛋白胨牛肉膏培养基培养出来的片状菌是什么菌
图片尺寸1500x1125
senge64 表面接触皿
图片尺寸711x502
空白
图片尺寸634x480
三倍空白培养基黄了,单倍空白培养基没事,最可能是什么原因?杜氏小
图片尺寸600x800
空白染菌,培养基染菌
图片尺寸2560x1440
第五步:培养结束,记录稀释倍数和相应平板上的菌落数;第四步:待培养基
图片尺寸750x421
【有图】 本帖最后由 瞑王殿下 于 2012-9-21 09:14 编辑 空白无菌
图片尺寸1024x768